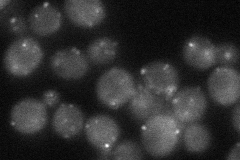
YDR244W

View description
Peroxisomal membrane signal receptor for the C-terminal tripeptide signal sequence (PTS1) of peroxisomal matrix proteins, required for peroxisomal matrix protein import; also proposed to have PTS1-receptor independent functions
Localization:
Intensity:
Fold change:
Significance:
-
C’ GFP library in SD

punctate24.97 -
N' NOP1pr-GFP in SD

punctate71.6123 -
N' TEF2pr-mCherry in SD

cytosol89.8795 -
N' NATIVEpr-GFP in SD
punctate40.3077 -
N' TEF2pr-VC and Cyto-VN in SD

punctate43.1118 -
C’ GFP library in SD+DTT

punctate19.20.76Yes -
C’ GFP library in SD+H2O2

punctate21.770.87No -
C’ GFP library in Starvation Media

punctate17.050.68Yes -
C’ GFP library on the background of Pup2-DaMP

N/A -
C’ GFP library on the background of CCT mutant

N/A0N/AYes
